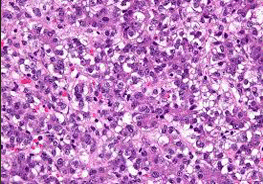
Hepatoblastoma

Dr. Nandini Choudhury Hazarika
Oncologist for Paediatric Cancer Treatment in Delhi NCR
A well-recognized Pediatric Medical oncologist and hematologist practicing in New Delhi. In my career of 20 years in this field of pediatric Medical oncology and hematology, I have treated all kinds of hematological and solid cancers and have a keen interest in neuro-oncology. I have done more than 150 bone marrow transplant in last 8 years for both non- malignant and malignant conditions like thalassemia, aplastic anemia,, metabolic disorders, leukemias, lymphomas, Ewing’s sarcoma, brain tumors, neuroblastoma etc.
After completing MD in Pediatrics from Assam Medical College in 2000, I did mypediatric oncology fellowship training from Kidwai Memorial Institute of Oncology, Bangalore(2001-2002) followed by needful 3 years residency in Medical and Pediatric oncology from Dr B Barooah Cancer Institute, Guwahati, Assam, 2003-2005,(a unit of Tata Memorial Hospital, Mumbai) and Medical oncology fellowship from Prince Aly Khan Hospital, Mumbai, India. I have done my BMT training at Prince Aly Khan Hospital, Mumbai (2006 to 2009) under Dr TapanSaikia and BMT observership at Duke Medical Center USA. Best Pediatric Oncologist in Delhi NCR.
Call Us For Any Inquries
+91-96508 06846
Pediatric Hematology
Childhood Cancers – Improving Cure and Transforming Care
Availability
- Monday, Tuesday, Thursday and Saturday - Rainbow
- Wednesday and Friday - Crest Galaxy cancer care, Moradabad
Childhood Cancers – Improving Cure and Transforming Care
Though the cancer in children is rare and it accounts for a small percentage (4-5%) of all cancers, the childhood cancer incidence is on the rise. In India around 50,000 new cases of cancer in children are diagnosed every year. Fortunately, a lot of progress has been made in the treatment of childhood cancer in recent decades.
Almost more than 80% of children with cancer can get cured if they are diagnosed on time and receive appropriate treatment. Though the outcome is very good, the treatment itself is intense and lengthy, continuing for at least 6 months to 2 years depending on the type and stage of cancer. During the treatment period the child misses out on regular activities, like going to school, playing with friends, visiting places, etc. Sometimes the kids have to travel to faraway places for better treatment, away from the comfort and warmth of their siblings and family. Moreover, the treatment also has some kind of implications on the physical appearance like hair loss, weight loss, surgical scar etc.
Read More

Frequently Asked Questions
Other common cancers in children include lymphoma (cancer involving the lymph nodes), brain tumors, bone tumors, tumors of kidney or adrenal gland, soft tissue sarcomas, tumors involving the eyes, liver etc.
- Prolonged fever for more than 2-3 weeks which is not controlled with routine medications and no definite cause of fever is detected.
- Painless swelling in the neck or axilla, increasing in size or associated with fever, cough, weight loss etc.
- Bluish or black spots over body, bleeding from gums or nose.
- Early morning vomiting or persistent headache, changes in eye, abnormal gait
- Abdominal swelling
- Joint pains associated with fever and pallor
Symptoms are usually dependent on the type of cancer. These symptoms can occur in other diseases also, but a little bit of alertness on the parts of the parents and the pediatricians is never a waste.
However, it is always advisable to follow a healthy balanced diet, regular physical activities and stay away from junk foods, obesity and constipation. It is a fact that obesity in childhood can lead to increased risk of cancer in adulthood. Environmental pollution may have some effect on gene mutation leading to rise in the cancer incidences in children. It can never be an overage to mention that nutrition plays an important role in cancer prevention and treatment.

GET A FREE QUOTE
WE ALWAYS USE BEST & FASTEST FLEETS
For enquiries, bookings or support, call us at +91-96508 06846
Need help? Get a call back from our support team
Contact Us